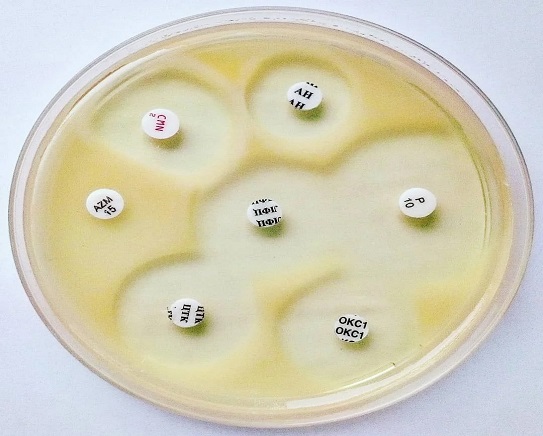

Muller Hinton Agar Plate
Mueller and Hinton developed Mueller Hinton Agar (MHA) in 1941 for the isolation of pathogenic Neisseria species. Nowadays, it is more commonly used for the routine susceptibility testing of non-fastidious microorganism by the Kirby-Bauer disk diffusion technique. Five percent sheep blood and nicotinamide adenine dinucleotide may also be added when susceptibility testing is done on Streptococcus species. This type is also commonly used for susceptibility testing of Campylobacter.
